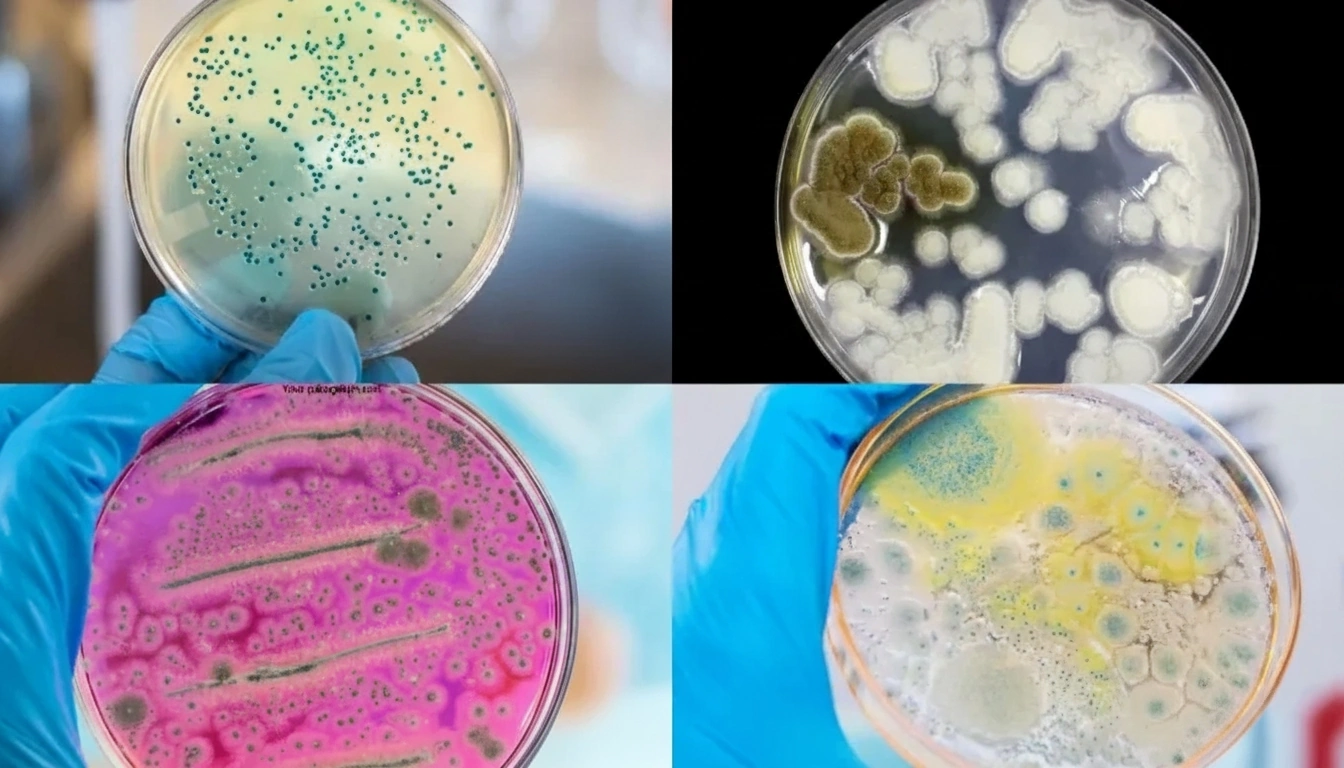

Les spécialistes révèlent : la vérité cachée sur l’épidémie bactérienne dans les foyers modernes et les 3 erreurs de nettoyage qui aggravent la situation !
Si vous avez remarqué que votre famille tombe plus souvent malade, que des odeurs persistantes ne disparaissent jamais ou que des allergies inexpliquées semblent s’aggraver à la maison, ce que vous êtes sur le point de découvrir pourrait bien sauver la santé de votre famille.
Le mois dernier, j’ai eu un accès exclusif à un symposium à huis clos dans un grand institut de recherche médicale, où les principaux spécialistes des maladies infectieuses se sont réunis pour discuter d’une découverte alarmante, qualifiée de « crise sanitaire cachée des foyers modernes ».
Ce qu’ils ont révélé m’a laissé sans voix — et terrifié pour ma propre famille.
Un chercheur principal en microbiologie environnementale d’une université de premier plan a présenté des données qui ont fait haleter même les experts les plus chevronnés :
« Nous observons aujourd’hui des colonies bactériennes dans les foyers qui sont 300 % plus résistantes que celles que nous avons documentées il y a seulement cinq ans. Et le pire ? Les méthodes de nettoyage traditionnelles les rendent en réalité plus fortes. »
La salle est restée silencieuse.
Puis il a lâché la bombe :
« Votre maison abrite probablement entre 7 000 et 10 000 espèces bactériennes différentes à l’heure actuelle. La plupart sont invisibles. Beaucoup sont dangereuses. Et presque toutes prospèrent à cause de trois erreurs critiques que presque tout le monde commet lors du nettoyage. »

Les 3 erreurs de nettoyage qui transforment votre maison en terrain fertile pour les bactéries
Erreur n°1 : utiliser les mêmes outils de nettoyage partout

« C’est une contamination croisée bactérienne puissance mille », expliqua le chercheur principal, en montrant des images microscopiques qui ont mis plusieurs participants mal à l’aise.
Lorsque vous utilisez la même éponge, le même chiffon ou la même brosse pour nettoyer plusieurs surfaces, vous ne nettoyez pas — vous répandez une autoroute bactérienne dans toute la maison.
Les images montraient comment les bactéries d’une brosse de toilettes utilisée une seule fois se retrouvent sur :
- Les plans de travail de la cuisine (là où vous préparez la nourriture)
- Les poignées de porte (touchées plus de 50 fois par jour)
- Les interrupteurs (jamais correctement nettoyés)
- Les jouets des enfants (directement dans leur bouche)
Erreur n°2 : croire que « propre en apparence » signifie réellement propre

Sophie Martin, une experte de premier plan en immunologie pédiatrique dans un grand institut de santé infantile, a présenté des résultats particulièrement inquiétants :
« Nous avons testé 100 maisons “impeccables”. Toutes ont échoué à nos normes de sécurité bactérienne. Ce qui semble propre à vos yeux est souvent une véritable métropole de micro-organismes dangereux. »
Elle montra des images avant/après obtenues grâce à un équipement de détection spécialisé. Les surfaces qui paraissaient impeccables s’illuminaient comme des sapins de Noël sous un scanner bactérien — révélant des colonies de :
- Bactéries nocives (provoquant des troubles digestifs sévères)
- Microbes dangereux (entraînant des infections cutanées)
- Agents responsables d’intoxications alimentaires
- Moisissures microscopiques (déclenchant des problèmes respiratoires)
Erreur n°3 : frotter avec une force et une vitesse insuffisantes
« Voici ce que personne ne comprend », expliqua le microbiologiste principal en démontrant avec une brosse de nettoyage standard.
« Le frottement manuel atteint à peine 20 à 30 rotations par minute. Les biofilms — ces boucliers protecteurs que les bactéries créent — nécessitent au moins 195 rotations par minute pour être brisés. »
Cela signifie qu’à chaque nettoyage manuel, vous laissez derrière vous jusqu’à 80 % des bactéries, protégées par une armure invisible qui se renforce à chaque tentative ratée.

La découverte qui a bouleversé tout ce que l’on croyait savoir sur le nettoyage
Il y a six mois, des chercheurs du Clean Living Laboratory d’une université prestigieuse ont fait une découverte qui révolutionne la manière dont les professionnels de l’hygiène conçoivent le nettoyage domestique.
Ils ont découvert qu’en combinant trois éléments spécifiques, on pouvait éliminer jusqu’à 99,7 % des bactéries domestiques :
- Force rotationnelle précise (195–235 tr/min)
- Répartition ciblée de la pression (grâce à un angle ergonomique ajustable)
- Détection visuelle de la contamination (grâce à la technologie UV)

« C’était comme redécouvrir les antibiotiques », déclara Lisa Park, chercheuse principale de l’étude. « Nous avions enfin trouvé un moyen de gagner la guerre contre les bactéries domestiques. »
La solution japonaise qui sauve des familles
Lors du deuxième jour du symposium, nous avons rencontré Kenji Nakamura, le principal expert japonais en technologies d’hygiène, venu spécialement pour cette présentation.
« Au Japon, nous avons éliminé ces problèmes il y a des décennies », dit-il avec assurance. « La solution n’est pas de travailler plus dur — c’est de travailler plus intelligemment. »
Il présenta alors le Synoshi Pro — un appareil qui semblait tout droit sorti d’un établissement médical plutôt que d’un foyer.
En quelques semaines après son lancement international, le Synoshi Pro a explosé dans les médias du monde entier.
Les grandes chaînes d’information ont diffusé des reportages montrant des présentateurs choqués découvrant la contamination invisible grâce à la lumière UV.
Le Synoshi Pro est devenu viral sur TikTok avec plus de 47 millions de vues, tandis que les experts du nettoyage sur YouTube l’ont qualifié de « révolutionnaire ».
« C’est le résultat de 15 ans d’innovation japonaise en matière de nettoyage, désormais renforcée par des recherches médicales de pointe », expliqua Nakamura.
Le Synoshi Pro : la défense de votre famille contre l’invasion bactérienne
Le Synoshi Pro n’est pas un simple outil de nettoyage — c’est un système complet d’élimination bactérienne qui corrige toutes les erreurs que les familles commettent.
Technologie révolutionnaire à triple vitesse
- Vitesse basse (195 tr/min) : nettoie en toute sécurité les surfaces délicates sans les abîmer
- Vitesse haute (235 tr/min) : détruit les biofilms tenaces et les bactéries incrustées
Fonctionnalités avancées qui font du Synoshi Pro une véritable révolution du nettoyage :
✅ Système de détection UV – le véritable atout : révèle ce que vos yeux ne peuvent pas voir — éclaboussures invisibles autour des toilettes, bactéries cachées sur des surfaces “propres”, moisissures dans les joints et contamination sur des objets du quotidien comme les porte-brosses à dents. Pour la première fois, vous pouvez réellement voir ce que vous combattez — c’est comme avoir une vision nocturne pour la saleté.
✅ Design ergonomique multi-angle : trois positions réglables (0°, 36°, 72°) éliminent les douleurs dorsales dues aux flexions. Nettoyez sans effort sous les toilettes, derrière les robinets et dans les coins. Le manche extensible atteint même les plafonds ou les fenêtres hautes sans échelle.
✅ Système d’attache rapide : inclut plusieurs têtes de brosses spécialisées pour chaque tâche. Chaque paire est codée par couleur afin de ne jamais confondre les outils de la salle de bain avec ceux de la cuisine. Les poils fermes s’attaquent aux joints et au carrelage, les têtes souples s’occupent des surfaces délicates, les brosses d’angle atteignent les recoins, et les brosses plates couvrent de grandes zones rapidement.
✅ Conception de qualité professionnelle : jusqu’à 2,5 heures d’autonomie (trois fois plus qu’un nettoyeur classique), entièrement étanche pour une utilisation dans la douche ou à l’extérieur, poids léger de 414 g qui ne fatigue pas les bras, sans fil pour une liberté totale, et matériaux antimicrobiens durables pour une manipulation plus propre à chaque usage.
Des familles réelles, des transformations réelles :

« Je vois des infections tous les jours à l’hôpital. Savoir ce qui se cache dans les maisons me terrifiait. Le Synoshi Pro m’apporte une véritable tranquillité d’esprit. La lumière UV a révélé de la contamination sur des surfaces que je croyais stériles. Maintenant, je sais que ma maison est réellement propre. »
Claire D.

« En tant que mère très occupée, je pensais que ma maison était propre, mais après avoir lu tous ces faits sur les bactéries cachées, j’étais inquiète. La lumière UV du Synoshi Pro a été une véritable révélation ! Maintenant, je peux voir ce que je nettoie, et j’ai l’esprit tranquille en sachant que ma famille vit dans un environnement réellement hygiénique. Cela a tout changé ! »
Élodie M.

“My back and knees made scrubbing on the floor impossible, and I was constantly worried about the hidden bacteria I just couldn’t reach. The Synoshi Pro’s extendable handle has been a true blessing. I can finally clean everything, from high windows to bathroom corners, without bending or straining. Now I have peace of mind knowing my home is truly hygienically clean.”
Linda M.
Offre limitée : liquidation d’entrepôt à -70 %
En raison d’une demande massive après les recommandations de la communauté médicale, les stocks de Synoshi Pro sont critiquement bas.
Le fabricant a autorisé une remise exceptionnelle de 70 % sur les dernières unités disponibles dans leur entrepôt européen — mais seulement jusqu’à épuisement des stocks.
Voici ce que vous recevez avec votre commande aujourd’hui :
✅ Appareil Synoshi Pro
✅ 4 têtes de brosses spécialisées
✅ Système de détection UV (intégré)
✅ Garantie de remboursement de 60 jours
✅ Expédition prioritaire gratuite

Le Synoshi Pro est-il fait pour votre famille ?
Posez-vous ces questions :
- Quelqu’un dans votre foyer souffre-t-il d’allergies ou tombe-t-il souvent malade ?
- Les mauvaises odeurs reviennent-elles malgré le nettoyage ?
- En avez-vous assez de frotter pendant des heures pour un résultat minime ?
- Vous inquiétez-vous de ce qui se cache réellement sur vos surfaces “propres” ?
- Le nettoyage devient-il physiquement difficile à cause du dos ou des genoux ?
- Dormiriez-vous mieux en sachant que votre maison est réellement exempte de bactéries ?
Si vous avez répondu OUI à l’une de ces questions, le Synoshi Pro n’est pas simplement recommandé — il est essentiel.
En résumé : la santé de votre famille n’est pas négociable
Chaque jour que vous attendez est un jour de plus où votre famille est exposée à des bactéries dangereuses qui se multiplient chez vous.
Chaque séance de nettoyage traditionnelle peut aggraver le problème.
Chaque maladie aurait pu être évitée.
Les mots du chercheur principal au symposium résonnent encore :
« Dans dix ans, nous regarderons le nettoyage manuel comme nous regardons aujourd’hui le fait de ne pas se laver les mains avant une opération — dangereux et primitif. »
Ne laissez pas votre famille faire partie des statistiques. Agissez maintenant — avant qu’il ne soit trop tard.

Mise à jour : En raison d’une forte demande, les stocks du Synoshi Pro sont presque épuisés. Les dates de réapprovisionnement sont incertaines, donc si les stocks s’écoulent, les délais de livraison pourraient être plus longs que prévu. Pour éviter tout retard, assurez-vous d’obtenir le vôtre tant qu’il est encore disponible.
MENTIONS LÉGALES :
Nom et forme de l’entreprise : UAB Convenity, une société à responsabilité limitée, dont la forme juridique est une société par actions
Adresse du siège social enregistré : Gedimino g. 45-7, LT-44239 Kaunas, Lituanie
Numéro d’entreprise : 306178201
Code de TVA enregistré : LT100015603714
Directrice générale de l’entreprise : Gintarė Stundytė
Téléphone : US +1 (218) 900-2005
E-mail : [email protected]
AVERTISSEMENT SANTÉ : Le Synoshi Pro est un appareil de nettoyage domestique conçu pour aider dans les tâches ménagères quotidiennes. Lorsqu’il est utilisé correctement, il peut réduire la saleté visible et invisible, mais ce n’est pas un dispositif médical et il n’est pas destiné à diagnostiquer, traiter, guérir ou prévenir des maladies. Les résultats peuvent varier en fonction de l’utilisation, de la surface et de l’environnement domestique. Suivez toujours les instructions du fabricant et continuez à respecter les mesures d’hygiène et habitudes de nettoyage recommandées par les autorités sanitaires.
AVERTISSEMENT PUBLICITAIRE : Ce site web ainsi que les produits et services qui y sont présentés font partie d’une plateforme publicitaire payante. Les contenus présentés ne doivent pas être interprétés comme des évaluations objectives de produits ou des conseils aux consommateurs. Ils servent exclusivement à des fins marketing, et toutes les informations relatives aux produits doivent être vérifiées indépendamment. Toutes les personnes représentées sur ce site sont des modèles et servent uniquement à des fins d’illustration.
AVERTISSEMENT MARKETING : Ce site web agit comme une place de marché en ligne. L’exploitant du site entretient une relation financière avec certains ou tous les produits et services présentés et peut recevoir une rémunération lorsqu’une interaction de l’utilisateur génère un prospect qualifié. Cette rémunération n’influence ni les contenus, ni les thèmes, ni les produits présentés. Toutes les informations relatives à TrackIO doivent être vérifiées directement auprès du fabricant ou du vendeur avant toute décision d’achat.
© 2026 Tous droits réservés